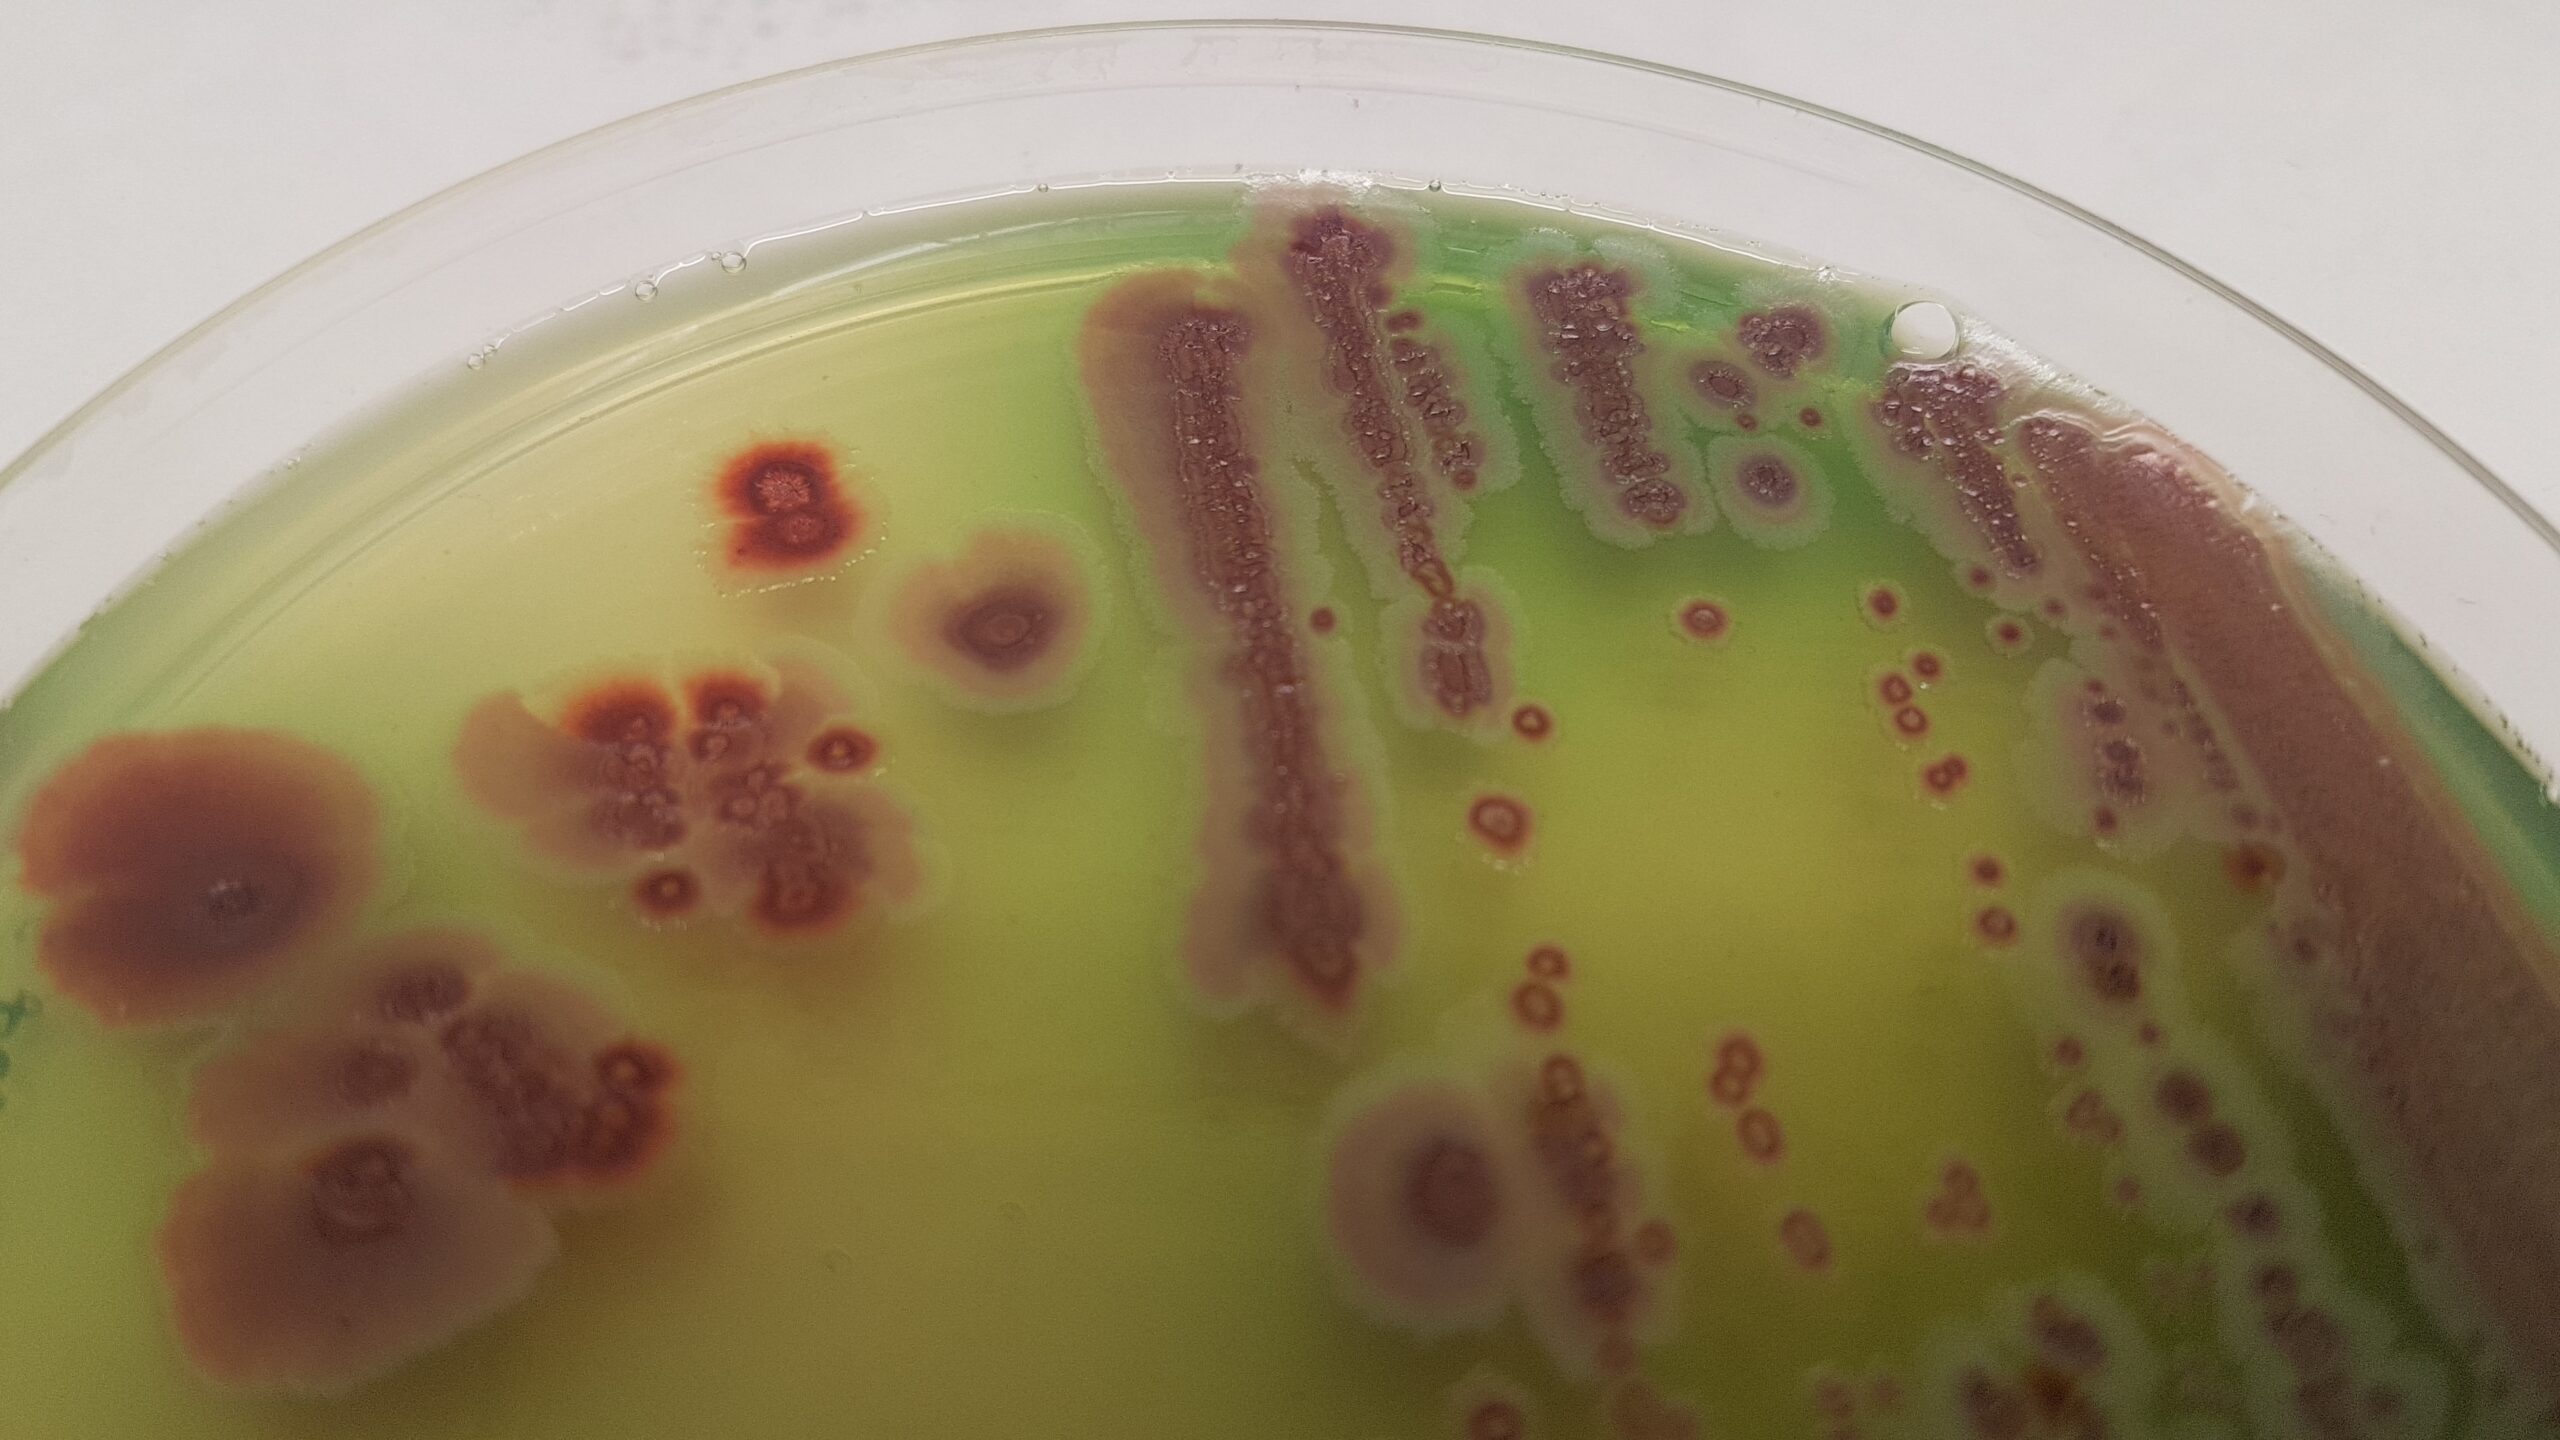
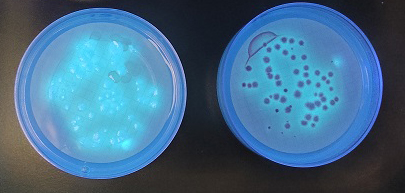

CROMOKIT PSEUDOMONAS CETRIMIDA Y CN AGAR CROMOGÉNICOS
CROMOKIT PSEUDOMONAS: DOS MEDIOS RÁPIDOS PARA PSEUDOMONAS AERUGINOSA CON LAS VENTAJAS DEL CETRIMIDA Y CN CLÁSICOS, EN SÓLO 18 HORAS
CROMOKIT PSEUDOMONAS CETRIMIDA y CN AGAR CROMOGÉNICOS son dos medios de cultivo rápidos para la detección y recuento de Pseudomonas aeruginosa en cosméticos y aguas respectivamente, con las ventajas de los dos medios clásicos, sumadas a la rapidez en el descarte de muestras negativas en sólo 18h en vez de las 48 h de los mismos medios clásicos.
Los rápidos en 18h:
Tiempos clásicos, tiempos modernos
Tanto en cosméticos como en aguas envasadas y de baño, la búsqueda de Pseudomonas aeruginosa suele tardar:
-4 días en el primer caso (2 son enriqueciendo en caldo neutralizante y 2 de estría en placa del caldo enriquecido) y
-2 días en aguas por filtración de membrana.
Gracias a la simple adición de un cromógeno en ambos medios, las colonias de Pseudomonas aeruginosa crecen rojas en sólo 18 h, contrastando de forma excelente con la membrana, mientras en los medios clásicos todavía no se alcanzan a ver.
La ventaja es que en las primeras 18 h desde la siembra en placa, ya sabemos qué muestras no contienen este patógeno: no hay colonias rojas.
¿Y en caso de presuntos positivos?
Si aparecen colonias rojas, podrían ser falsos positivos, y sólo en este caso hay que esperar otras 18 h para poder observar si alrededor de las colonias hay un halo fluorescente verde, amarillo o azul, propios de Pseudomonas aeruginosa.
Hacer la prueba de la oxidasa no es redundante, porque si bien el Cetrimida y el CN son dos medios bastante selectivos, hemos visto a veces crecimiento de coliformes e incluso de Gram positivos como Bacillus spp:
.
Si aparecen en las primeras 18h colonias rojas, oxidasa positivas, la simple
prueba de Acetamida con reactivo Nessler nos sacará definitivamente de dudas:
Si precipita a marrón-naranja nada más añadir el reactivo al tubo de Acetamida (previamente incubado con la colonia sospechosa), se trata sin duda de Pseudomonas aeruginosa.
Además, mientras incubamos el tubo de Acetamida, seguiremos incubando la placa de Cromokit Rapid Cetrimida o de Cromokit Rapid CN con colonias rojas…
,,,y al mismo tiempo de ver la prueba de la Acetamida, podremos observar si aparece halo fluorescente alrededor de las colonias rojas, señal de que se trata de Pseudomonas aeruginosa.
Dcha: Agar Rapid Cetrimida cromogénico
¿En caso de presuntos positivos no habremos ganado tiempo?
En estos 4 medios (tanto los 2 clásicos como los 2 cromogénicos) pueden haber falsos positivos de Ps.fluorescens y de Ps.putida, que también generan colonias características, si bien su fluorescencia es bastante más tenue que en el caso de Ps.aeruginosa.
Y tambien falsos positivos de otros Gram negativos no fermentadores.
Para acelerar también en el caso de que aparezcan presuntos positivos, contamos con las galerías enzimáticas Rapid NF, que en sólo 4 horas nos van a decir de qué especie de No fermentador se trata, sea o no sea una Pseudomonas.
De modo que en el peor de los casos, vamos a saber si tenemos o no Pseudomonas aeruginosa en nuestras muestras de cosméticos o de aguas en sólo 18+4 horas tras la siembra en placa, es decir, en menos de 24 horas.
.
Estas son las fichas técnicas de los avances comentados:
Para cosméticos:
https://www.microkit.es/fichas/CROMOKIT-RAPID-PSEUDOMONAS-AGAR.pdf
Para aguas:
https://www.microkit.es/fichas/CROMOKIT-RAPID-CN-PSEUDOMONAS-AGAR.pdf
Para confirmar presuntos positivos de 18h:
https://www.microkit.es/fichas/CITOCROMO-OXIDASA-M-IDENT-ISO-16266–ISO-16649.pdf
o bien:
https://www.microkit.es/fichas/Citocromo-oxidasa–reactivo-en-goteros-para-banar-placas.pdf
Y además, para potenciar la visión de la fluorescencia:
https://www.microkit.es/fichas/LINTERNA-ULTRAVIOLETA-DE-366%20nm.pdf
Y después:
https://www.microkit.es/fichas/ACETAMIDE-BROTH.pdf
O más rápido, desde las colonias rojas de 18 horas, usar directamente Rapid-NF 4 horas:
https://www.microkit.es/fichas/Galerias-RAPID.pdf
total: 18 horas si no aparecen colonias rojas y 22 horas si aparecen colonias rojas
Solicite los precios actualizados en microkit@microkit.es
Si tiene dudas técnicas contacte con consultastecnicas@microkit.es
Haga sus pedidos en pedidos@microkit.es
Prepárese para más de una sorpresa informativa cuando vea nuestro video sobre los medios Cromogénicos: https://www.youtube.com/watch?v=-JVPVWxY8ZE&t=271s